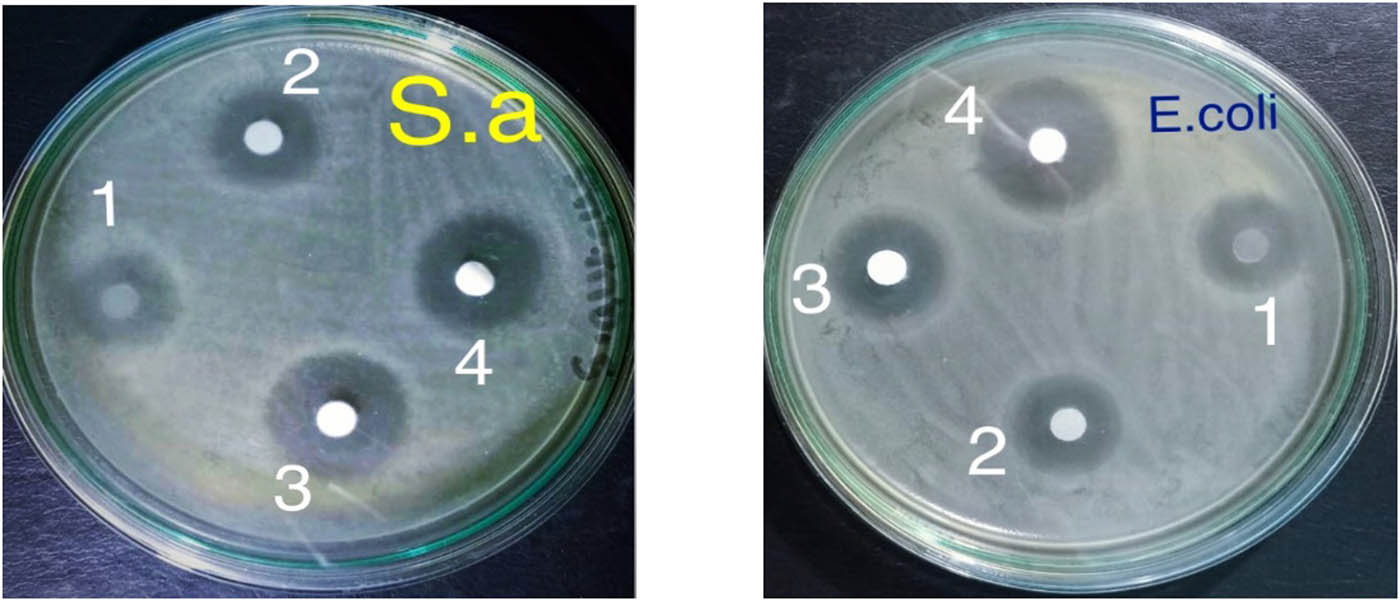

Abstract
Edible films from carboxymethyl cellulose (CMC)/starch incorporated with titanium dioxide (TiO2) nanoparticles were developed. The prepared films were characterized by Fourier transforms infrared, X-ray diffraction, transmission electron microscopy, dynamic light scattering, swelling behaviour, and thermal and mechanical properties. Results showed a decrease in the average particle size of TiO2 nanoparticles with increasing irradiation dose up to 30 kGy. The swelling capacity of CMC/starch blends is ordered in the sequence of composition ratio 2:1 > 1:1 > 1:2. The effect of different irradiation doses (2.5, 5, 10, 15, and 20 kGy) and different concentrations of TiO2 (0.5, 1, 1.5, 2, 2.5, and 3 wt%) on the film properties was evaluated. The tensile strength increased gradually, accompanied by a decline in elongation percentage with the increase in the irradiation dose and increase in the TiO2 contents up to 2.5 wt%. The irradiated CMC/starch/TiO2 film showed higher thermal stability than CMC/starch film. Furthermore, the unirradiated and irradiated CMC/starch/TiO2 edible films were applied to fresh strawberries by surface coating. The irradiated film showed a superior effect in prolonging the fruits’ shelf life. The antimicrobial activity of CMC/starch/TiO2 film against Escherichia coli and Staphylococcus aureus was increased by increasing the irradiation dose. In conclusion, CMC/starch/TiO2 edible film exhibited the prerequisite behaviour for potential application in active food packaging.
1 Introduction
Edible surface coating is widely used to delay food deterioration and extend its shelf life. It can be used as a thin film that is applied directly on the food surface and acts as a barrier to moisture and oxygen flow, reducing respiration rates, minimizing water loss, and maintaining food freshness for a prolonged period. Recent food packaging trends are shifting towards natural and environmentally friendly biodegradable packaging films as a green alternative to the conventionally used plastic and paper packaging materials because of the unfavourable impact of synthetic materials on the environment [1]. Edible films can be synthesized using polymers such as polysaccharides, cellulose derivatives, mucilage, albumin, pectin, or gelatin. Polysaccharides are frequently used in the preparation of edible packaging as they are colourless and tasteless and have good oxygen and carbon dioxide barriers [2].
Starch has received a great deal of interest in edible food packaging because it is a renewable natural polysaccharide with relatively low cost and abundant availability. It is biodegradable and breaks down to produce eco-friendly products such as carbon dioxide and water [3]. It can be easily cast into films; however, starch-based films have some limitations, including low moisture resistance and mechanical properties. Therefore, numerous studies have been conducted on starch modifications, such as blending with other polymers to improve starch films’ thermal and mechanical properties [4].
Cellulose is the most abundant polysaccharide present in nature. Carboxymethyl cellulose (CMC), a water-soluble cellulose derivative, is suitable for food packaging due to its good film-forming ability, non-toxicity, biodegradability, and cost-effectiveness [5]. It has a linear chain polymer structure with a high molecular weight. Depending on their concentration and interaction with the polymer matrix, these characteristics could improve starch-based films’ mechanical and barrier properties [6]. Previous studies have investigated the impact of CMC on starch films and demonstrated the production of a single-phase complex due to the chemical compatibility between starch and CMC, leading to the enrichment of mechanical and moisture resistance [7,8].
Notably, food deterioration caused by food-borne pathogens and microorganisms is a growing concern in the food industry. Therefore, a highly encouraging active packaging innovation is an antimicrobial packaging system that incorporates antimicrobial agents into a polymer film to inhibit bacterial growth, extend the product’s shelf life, and enhance food safety [9]. Due to its photocatalytic reaction, titanium dioxide (TiO2) exhibits high antibacterial properties against a wide spectrum of Gram-positive and Gram-negative bacteria [10]. TiO2 is considered a safe material by US FDA and has been approved for use in drugs, cosmetics, and food packaging. Indeed, there is an increasing interest in the applications of TiO2 in the food industry due to its excellent antimicrobial activity. Notably, the use of nano-scaled TiO2 has the potential to enhance its antimicrobial activity. TiO2 nanoparticles have been incorporated in CMC/starch polymeric matrix to develop CMC/starch/TiO2 edible film. Irradiation with visible or UV light activates the photocatalytic reaction of TiO2, generating reactive oxygen species, such as hydroxyl (˙OH) and superoxide radicals (O2 −), on the surface of TiO2. These radicals have strong oxidizing power and are responsible for inactivating pathogens by oxidizing the polyunsaturated phospholipid components of the cell membrane of microbes [11].
Irradiation techniques have been used for modifying polymers, for which γ radiation is a clean source for initiation and crosslinking through the generation of free radicals at the boundary surfaces of the polymer, leading to the development of covalent bonds or crosslinked structure [12].
In the current study, edible CMC/starch blends of different compositions (1:1, 1:2, and 2:1) were prepared, and TiO2 nanoparticles were synthesized using a γ-irradiation technique as a clean tool for polymerization and crosslinking. The preparation conditions were optimized, and the designed blends were characterized by swelling behaviour, Fourier transforms infrared (FT-IR), X-ray diffraction (XRD), transmission electron microscopy (TEM), dynamic light scattering (DLS), and thermal and mechanical properties. The impact of different particle sizes and different concentrations of TiO2 in the colloidal solution on the thermo-mechanical properties of the developed films was estimated. Furthermore, the effect of different doses of γ rays on the mechanical and thermal behaviour of CMC/starch/TiO2 film was examined. The present study’s objective was to investigate the efficiency of CMC/starch/TiO2 edible films to improve the quality and shelf life of strawberries. Furthermore, the antimicrobial activity of the developed CMC/starch/TiO2 edible films was evaluated for food-packaging applications.
2 Materials and methods
2.1 Materials
Titanium isopropoxide 95% was supplied from Alfa Aesar, Germany. CMC was purchased from El-Naser CO, Egypt. The Egyptian Company provided maize starch containing 27% amylose and 73% amylopectin for Starch and Glucose, Cairo, Egypt. Glycerol 99.5% (Mwt, 92.09) was purchased from El-Gomhouria CO, Egypt. Citric acid was provided from Loba Chemie PVT. LTD, Mumbai, India.
2.2 Irradiation facilities
The irradiation process was carried out using a Canadian Gamma Cell‐40 biological irradiator with 60Co irradiation sources belonging to the National Center for Radiation Research and Technology, Atomic Energy Authority, Cairo, Egypt.
2.3 Preparation of TiO2 nanoparticles
A 10 mL titanium isopropoxide, 95%, was added dropwise to 60 mL of 0.1 M nitric acid solution under vigorous stirring at ambient temperature. Hydrolysis of titanium isopropoxide offered a white precipitate that was heated to 80°C for almost 8 h with stirring to accomplish peptization. Next, the obtained colloidal solution of TiO2 nanoparticles was irradiated using 60Co gamma rays with different doses of 10, 20, and 30 kGy, delivered at a dose rate of 0.56 Gy·s−1 to study the effect of γ rays on the particle size of TiO2 colloidal solution. Then, the resultant solution was filtered and dried. Finally, several techniques were employed to characterize the obtained TiO2 nanoparticles. Samples using 30 kGy showed the smallest particle size; thus, such doses were selected for further experiments.
2.4 Preparation of CMC/starch blends
The solution casting method prepared a series of CMC/starch blends with various compositions. Briefly, 1.5 wt% CMC aqueous solution was prepared at 80°C with stirring until complete dissolution. The starch solution was prepared by dispersing 1.5 wt% starch in distilled water and heating it to 80°C with constant stirring until complete starch gelatinization. CMC/starch blends were prepared by mixing the CMC solution with a starch solution at different copolymer compositions of 1:1, 1:2, and 2:1. Then, 1.5 wt% of citric acid as a crosslinker and 30% glycerol as a plasticizer were added under constant stirring at 80°C for 2 h until the blend changed into a homogenous mixture solution. Thin films were obtained by casting the blend solutions on Petri dishes of 25 cm diameter and allowing them to air dry. The CMC/starch blend film with a ratio of 1:2 was selected for further examinations due to its optimal swelling percentage.
2.5 Effect of TiO2 particle size on CMC/starch/TiO2 blend
The selected CMC/starch blend in the ratio of 1:2 was mixed with 0.5% TiO2 suspension that was irradiated at 10, 20, and 30 kGy with continuous stirring for 3 h at 80°C. The mixture was then sonicated for 30 min for blend homogeneity. As previously mentioned, films were obtained by casting the blends on glass Petri dishes.
2.6 Effect of TiO2 concentration on CMC/starch/TiO2 blend
The developed CMC/starch blend was mixed with different TiO2 nanoparticles (0.5, 1, 1.5, 2, 2.5, and 3 wt%) and stirred continuously at 80°C for 3 h followed by sonication to obtain homogenous blends. After that, CMC/starch/TiO2 blend solutions were cast into Petri dishes and allowed to dry in the air at room temperature. The gained films were characterized by mechanical properties. Based on the results of these studies, the superior blend concentration was chosen for additional investigations. Subsequently, the selected CMC/starch/TiO2 blend film was subjected to different gamma irradiation doses of 2.5, 5, 10, 15, and 20 kGy using 60Co γ rays.
2.7 Effect of irradiation dose on CMC/starch/TiO2 blend
A CMC/starch/TiO2 blend film with the selected TiO2 concentration was subjected to different gamma irradiation doses of 2.5, 5, 10, 15, and 20 kGy using 60Co γ rays to study the effect of irradiation dose on the thermal and mechanical characteristics of the films.
2.8 Characterization of CMC/starch/TiO2 blend films
2.8.1 FT-IR spectra analysis
The samples’ chemical structure and functional groups were identified using an FTIR-Vertex 70 spectrophotometer (Bruker, Karlsruhe, Germany) over the spectral range from 400 to 4,000 cm−1. The FTIR analysis was carried out in the Micro Analytical Center, Cairo University, Egypt.
2.8.2 XRD pattern
The samples’ crystalline characteristics were examined using a fully computerized X-ray diffractometer (Shimadzu type XD-DI), and the data were recorded. The scanned 2θ angle range of XRD patterns was 0–90° on a Philips PW 1730. X-ray generator was equipped with a scintillation counter at 40 kV voltage, filament current of 28 mA, and scanning speed of 20 mm·min−1.
2.8.3 TEM
A transmission electron microscope (JEOL, JEM100CS, Japan) was employed to characterize the particle size and morphology of TiO2 nanoparticles. Before being allowed to dry at room temperature, samples for TEM observation were diluted and fixed on carbon-coated copper grids.
2.8.4 DLS
The diameter and particle size distribution of the prepared TiO2 nanoparticles were measured by the DLS system using PSS-NICOMP particle sizer 380ZLS (PSS-NICOMP, Santa Barbara, CA, USA). All analyses were triplicated, with an average of three runs.
2.8.5 Swelling studies
The pre-weighed dried films were soaked in distilled water at 37°C. At certain time intervals, swollen films were removed, dried gently with filter paper, and weighed using a sensitive balance. The measurements were continued until the weight remained constant for each sample. The swelling ratio S% was determined according to the following equation:
where W s and W o are the weights of the swollen and the dried films, respectively, the experiments were triplicated, and the results were reported as average values.
2.8.6 Mechanical properties
Mechanical testing of samples, including tensile strength and elongation at breakpoints, was conducted at room temperature using an Instron Machine (model 1195, England) employing a crosshead speed of 10 mm·min−1 according to ASTM D-638 standards. The recorded value of the tensile strength and elongation at break was an average of five measurements.
2.8.7 Thermogravimetric analysis (TGA)
The thermal stability of samples was investigated by TGA analysis. The TGA thermograms were performed on a Shimadzu instrument (Kyoto, Japan) at a heating rate of 10°C·min−1 under flowing nitrogen (20 mL·min−1) from room temperature to 600°C.
2.8.8 Coating application on strawberries
Fresh strawberries were obtained from a local market, and only fruits that were uniform in size with a red colour surface and free of visible mechanical damage or fungal decay were selected for this study. Strawberries were dipped into the coating solutions for 5 min, the excess of these solutions was drained, and then the coated strawberries were air dried. All samples were stored at room temperature for 15 days for shelf life evaluation. Uncoated strawberries were used as controls.
2.8.9 Assessment of antimicrobial activity
The antibacterial activity of the CMC/starch/TiO2 blends was investigated against both Escherichia coli, Gram-negative bacteria, and Staphylococcus aureus, Gram-positive bacteria. Bacterial strains were collected from the Italian Hospital in Cairo. For routine use, the cultures were maintained on Luria-Bertani agar. Films were placed on Petri dishes containing the media, E. coli culture and S. aureus culture were then incubated at 37°C for 18 h. The inhibition zones were determined by milliliter and expressed as a percentage related to a broad-spectrum antibiotic (amoxicillin).
3 Results and discussion
3.1 FTIR spectroscopy
The characteristic broad absorption bands (Figure 1) observed at 3,319 and 3,356 cm−1 indicate the stretching vibration of hydroxyl (O–H) groups of starch and CMC, respectively. The bands were broad, which could be the result of hydrogen bonding interactions [13]. The overlap between hydroxyl groups of starch, CMC, glycerol, and citric acid causes this peak shift in the CMC/starch spectrum. The peak at approximately 2,920 cm−1 is assigned to alkyl (C–H) stretching vibration. The bands at 1,714 and 1,716 cm−1 refer to stretching vibrations of the carbonyl group (C═O) of starch and CMC, respectively; whereas the intensity of this band is associated with the degree of substitution [14]. The peak representing the carbonyl group is shifted to a higher frequency at 1,723 cm−1 in the CMC/starch blend, confirming a crosslinking reaction between polysaccharide derivatives with citric acid [15]. The peaks at 1,410 and 1,585 cm−1 correlate to the CMC molecule’s carboxyl group (COO–) [16]. The peak at 1,410 cm−1 was shifted to 1,403 cm−1 in the CMC/starch spectrum, demonstrating the interaction between the COO− a group of CMC and the O–H group of starch [17].

FT-IR spectra of pure starch, CMC, CMC/starch, and CMC/starch/TiO2.
The absorption bands at 1,336 and 1,210 cm−1 are attributed to bending vibrations of the CH2 and the OH groups, respectively. The stretching vibrations of C–O–C in starch and CMC are detected at 1,010 and 1,032 cm−1, respectively, suggesting the formation of stronger H– bonds between the starch molecules than between the CMC molecules, which might be due to a greater degree of substitution of CMC favouring the steric repulsion. These peaks were shifted toward lower wavenumbers at 1,008 cm−1 in the CMC/starch spectrum, reflecting the stability of hydrogen bonds formed between starch and CMC [18]. The characteristic peaks of CMC/starch are similar to the original starch and CMC but with a shift and broadening of the characteristic peaks indicating successful preparation of the CMC/starch blend.
It was demonstrated that the FTIR spectral analysis of CMC/starch/TiO2 was equivalent to CMC/starch with a minor difference in peak intensity, suggesting that the added TiO2 particles have not initiated vital changes in blend structure. The characteristic peak of CMC/starch/TiO2 at 607 cm−1 is related to Ti–O–Ti tensile vibration, confirming the formation of an inorganic matrix. The absorption peak at 899 cm−1 is due to Ti–O and Ti–O–Ti coupling vibration [19]. The peak observed at 3,296 cm−1 is likely a consequence of OH tensile vibration associated with water molecules in the TiO2 nanoparticle matrix. A peak that appeared at 776 cm−1 is conjugated with stretching vibration [20].
3.2 XRD analysis
As demonstrated in Figure 2, the XRD pattern of TiO2 displayed intense diffraction peaks at 2θ = 27.6°, 36.2°, 41.3°, and 54.5° corresponding to (101), (110), (200), and (211) crystal planes, respectively, which are consistent with the standard spectrum (JCPDS No.: 88–1175 and 84–1286) [21]. These characteristic peaks confirm the spinal structure of the Bragg reflections of TiO2. The XRD patterns of irradiated CMC/starch/TiO2 at 10, 20, and 30 kGy exhibited diffraction peaks at 2θ = 17.9° and 25.6°, revealing an amorphous or semi-crystalline structure. The amorphous nature of CMC/starch films was previously reported by other investigators [22]. The XRD patterns of irradiated CMC/starch/TiO2 showed a reduction in the crystallinity of the composite films with an increasing irradiation dose that could be ascribed to the formation of a crosslinked composite film. Moreover, the decrease in the film crystallinity might be attributed to the hydrogen bonding interaction between TiO2 with CMC and starch favouring their compatibility [23–26]. The average crystallite size of samples was calculated using the Scherrer equation [27]:
where D is the mean crystallite size, K is the shape factor and its value = 0.9, λ is the X-ray wavelength, β 2θ is the full width at half maximum intensity, and θ is the corresponding Bragg angle. The average crystallite sizes of TiO2 irradiated at 10, 20, and 30 kGy were found to be 40, 14, and 10 nm, respectively. Data revealed a decrease in crystal structure with an increasing irradiation dose and production of lower nanoparticle-sized TiO2. This behaviour is considered a good confirmation of the results shown on FTIR.

XRD curves of TiO2 nanoparticles and irradiated CMC/starch/TiO2 at 10, 20, and 30 kGy.
3.3 TEM imaging
Figure 3 shows that TiO2 nanoparticles irradiated at 10 kGy were in the size range of 31–60 nm with a mean size of 43 nm (Figure 3a). For TiO2 particles irradiated at 20 kGy, the size tended to be smaller, falling in the 11–19 nm range with an average size of 16 nm (Figure 3b). A further reduction in particle size was observed at 30 kGy, at which point the diameter was estimated to be in the size range of 8–18 nm with a mean size of 12 nm (Figure 3c). It seems that TiO2 nanoparticles obtained using 30 kGy exhibited the minor mean diameter, and therefore that dose was selected for further experiments. The decrease in average particle size with increasing irradiation dose is clearly noticeable. Such a change could be ascribed to the intramolecular crosslinked structure enhanced with radiation-induced polymerization, leading to a reduction in particle size. A similar phenomenon was observed by Pasanphan et al. [28], who reported a decrease in particle size with an increasing irradiation dose. However, the figure revealed a slight particle agglomeration that could contribute to the attractive electrostatic force between the nanoparticles due to the electric double layer on their surfaces [29]. These TEM observations support our XRD results.

TEM images of TiO2 nanoparticles at different irradiation doses: (a) 10 kGy, (b) 20 kGy, and (c) 30 kGy.
3.4 DLS
The diameter and particle size distribution of the prepared TiO2 nanoparticles were examined using the DLS technique to investigate the structural changes induced by different irradiation doses (10–30 kGy). At 10 kGy, the mean diameter measured by DLS was found to be around 62.4 nm, as displayed in Figure 4a. At 20 kGy, the particle size decreased, and the average hydrodynamic diameter was approximately 44.3 nm (Figure 4b). Meanwhile, the particle size decreased further at 30 kGy to around 23.7 nm, and the size distribution narrowed (Figure 4c). This decrease in the particle size could be attributed to degradation and intra-molecular crosslinking reaction, as previously reported [30,31]. The current findings demonstrated that irradiation dose significantly impacts the mean nanoparticle diameter, whereby the particle size decreases in response to an increasing irradiation dose. These results conform with our TEM observations. However, the particle size estimated by DLS was greater than that obtained by TEM, which could be partly attributed to measuring the sample size in an aqueous solution in DLS as opposed to a dried state in TEM, which led to water molecules being bound to nanoparticles and, in turn, to larger particle sizes.

DLS histograms of TiO2 nanoparticles at different irradiation doses: (a) 10 kGy, (b) 20 kGy, and (c) 30 kGy.
3.5 Swelling studies
The swelling behaviour of CMC/starch blends of different compositions of 1:1, 1:2, and 2:1 as a function of time is illustrated in Figure 5a. Data demonstrated a pronounced effect resulting from altering the feed solution composition. It can be observed that the moisture absorption capacity of CMC/starch blends is ordered in the sequence of composition ratio 2:1 > 1:1 > 1:2. The highest swelling efficiency was obtained at a higher CMC concentration, as is shown for the CMC/starch film with composition 2:1, which might be ascribed to the lower hydrogen bonding between the functional groups of CMC and starch and consequently the existence of a higher number of free hydrophilic functional groups in CMC resulting in more water uptake. The hydrogen bond between CMC and starch could produce an extensive framework capable of entrapping water in its amorphous region [32].

Swelling behaviour of CMC/starch blend at (a) different compositions and (b) different irradiation doses of selected CMC/starch (1:2).
The swelling behaviour was found to decrease with the reduction in CMC content, as depicted in the CMC/starch sample with a composition ratio of 1:1. This result could be explained by increasing the crosslinking reaction and hydrogen bond connections between the COO− groups of CMC and the OH− groups of starch, leading to a decrement in the blend’s hydrophilicity by consuming their hydrophilic functional groups. This coincided with the work of other investigators who reported comparable data [8,33,34].
The further increase in starch content in the feed solution led to a more significant reduction in the swelling behaviour, as presented in the CMC/starch film with composition 1:2. This might be a consequence of the high crystallinity of starch, which reduces the pore size and free spaces available to retain water molecules [35]. It has been well documented that the swellability of blend films is greatly dependent on their hydrogen bonding and crystalline structure [33,35]. Finally, a CMC/starch blend with a composition of 1:2 was selected due to its higher water resistance behaviour, which is required in packaging applications.
In addition, the effect of irradiation dose on the equilibrium swelling of CMC/starch film of ratio 1:2 is shown in Figure 5b. It can be seen that as the irradiation dose increased from 2.5 to 10 kGy, the moisture absorption capability decreased due to the formation of a more coherent crosslinked polymer structure by γ rays that rendered water penetration into the blend followed by elevation in swelling percentage due to degradation that occurred at high irradiation doses of 15 and 20 kGy. These findings align with previously reported results for poly (styrene/starch) blends [36].
3.6 Mechanical properties
Mechanical performance is one of the most critical factors affecting the properties of packaging materials and their applicability for practical use [37]. Notably, starch is known to have poor mechanical properties, and numerous efforts have been made to improve its mechanical characteristics, including incorporating nanofillers as TiO2 nanoparticles [38]. Mechanical properties are characterized by tensile strength (the maximum allowable strain pressure that a sample can withstand while being stretched without tearing apart) and elongation at break (a measure of the material ductility). Several structural factors influence the mechanical characteristics of materials. Among these factors are the chemical composition, crystallinity, plasticization, crosslinking, and copolymerization of such material.
Glycerol is widely used as a plasticizing agent in the development of starch-based films owing to its compatibility with amylose, which results in enhanced mechanical properties [39]. It has been previously reported that citric acid could provide starch/CMC film with the crosslinking effect and increase its tensile strength [40]. In the current study, the effect of the particle size of TiO2 that was irradiated at different irradiation doses (10, 20, and 30 kGy) on the mechanical properties of the selected CMC/starch/TiO2 blend with a composition ratio of 1%:2%:0.5% was studied. Figure 6a shows that the highest level of tensile strength and the lowest percentage of elongation was in the sample irradiated at 30 kGy, which exhibited the minor mean diameter for TiO2 nanoparticles according to TEM observations. The reinforcement of TiO2 nanoparticles in the blend could be related to the higher surface area of TiO2, leading to enhanced dispersion of TiO2 in the polymer matrix, enabling a solid interaction with CMC/starch [23]. The alteration of tensile strength values depends on the ability of the material to form strong molecular bonds. Nevertheless, the larger particle size of TiO2 that was irradiated at 10 and 20 kGy depicted a lower level of tensile strength that could be attributed to the uneven distribution of TiO2 nanoparticles in the polymer matrix. Based on these findings, the CMC/starch/TiO2 blend film that was irradiated at 30 kGy was selected for further examinations due to its optimal mechanical properties. Thus, it is conceivable to speculate that incorporating TiO2 nanoparticles improved the mechanical characteristics of the blend film.

Effect of TiO2 particle size (a), TiO2 contents (b), and irradiation dose (c) on mechanical properties of CMC/starch/TiO2 film.
The effect of adding different concentrations of TiO2 nanoparticles (0.5, 1, 1.5, 2, 2.5, and 3 wt%) on the mechanical behaviour of the CMC/starch/TiO2 blend was investigated and is displayed in Figure 6b. It was found that the tensile strength values increased in line with the increase in the contents of TiO2 nanoparticles up to 2.5 wt%, and then tensile strength tended to decline at higher contents. This elevation in tensile strength values upon increasing TiO2 contents might be explained based on the increasing compatibility between the blend’s constituents and their tendency to form solid molecular bonds, enhancing the film strength. In addition, the different functional groups provide more sites for crosslinking. It has been reported that a film’s mechanical properties greatly depend on the affinity between the film components [41]. When the affinity between the constituents increases, numerous stronger chemical bonds between the molecules are formed with a subsequently better film strength [42,43].
The elongation percentage at break decreased when the TiO2 content was raised to 2.5 wt%, which is possibly associated with the reinforcement effect of TiO2 nanoparticles in the blend leading to a reduction in elongation percentage. Indeed, the alteration in the film elongation depends on the degree of crosslinking within the polymer, which limits the polymer motion against the applied force [23]. Note that the tensile strength is reduced at higher TiO2 contents, which is possibly due to poor bonding at the interface. The current results indicated that TiO2 nanoparticles could modify the mechanical properties of the CMC/starch blend.
In addition, the effect of different irradiation doses (2.5, 5, 10, 15, and 20 kGy) on the mechanical properties of the selected CMC/starch/TiO2 blend (1:2:2.5 wt%) was studied and is illustrated in Figure 6c. It was found that irradiation strongly affected the mechanical behaviour of the CMC/starch/TiO2 blend. Increasing the irradiation dose increased the tensile strength gradually, accompanied by a decline in elongation percentage. This improvement in mechanical properties through radiation could be ascribed to the generation of free radicals that bind with TiO2 via an H-bond or bind together to form a crosslinking network within the CMC/starch matrix, which might restrict the mobility of the molecular chain [44]. At the same time, the tensile strength declined, and the elongation percentage rose in line with higher irradiation doses. This might be partly associated with the initiation of cracks and the degradation process induced by irradiation, which corroborates the swelling results.
3.7 TGA
The thermal stability of the prepared films is an important property to consider when assessing their suitability for use in the food industry because edible films could be exposed to heat during their preparation or consumption [45]. TGA is a well-established technique to estimate the thermal stability of polymers over a wide range of temperatures. The TGA thermograms and the rate of thermal decomposition (dw/dt) curves of the CMC/starch film and the CMC/starch/TiO2 films irradiated at 2.5 and 15 kGy within the temperature range of 100–600°C are shown in Figure 7, and the weight loss percentage as a function of temperature is listed in Table 1. The irradiated CMC/starch/TiO2 film showed lower weight loss than the CMC/starch film, suggesting that the incorporation of TiO2 significantly impacted the film thermal stability. This improvement in thermal stability could be related to the enhancement in hydrogen bonding interaction and compatibility between the TiO2 and CMC/starch polymer matrix, forming a highly crosslinked structure [24,25]. Thermal stability is a recognized tool for evaluating the miscibility of polymeric blends [46].

TGA thermograms and the rate of thermal decomposition (dw/dt) curves of CMC/starch and irradiated CMC/starch/TiO2 at 2.5 and 15 kGy.
Weight loss (%) of CMC/starch and CMC/starch/TiO2 irradiated at 2.5 and 15 kGy at different decomposition temperatures
| Sample | Dose (kGy) | Weight loss (%) | T max | |||||
|---|---|---|---|---|---|---|---|---|
| 100°C | 200°C | 300°C | 400°C | 500°C | 600°C | |||
| CMC/starch | 0 | 2.5 | 10.6 | 43.9 | 68.2 | 74.1 | 75.7 | 285 |
| CMC/starch/TiO2 | 2.5 | 0.8 | 9.3 | 44.2 | 66.4 | 71.3 | 72.3 | 293 |
| CMC/starch/TiO2 | 15 | 0.6 | 8.1 | 36.2 | 64.6 | 69.9 | 71.5 | 298 |
The lower weight loss for CMC/starch/TiO2 film can be explained based on the protective physical barrier effect of nanomaterial on the surface that prevents water evaporation and degradation products volatilizing from the film and consequently delays film degradation [47]. The thermal decomposition of CMC/starch blend film occurred in four main weight loss stages. The first stage started from room temperature up to 100°C with a weight loss of 2.5%, which is water evaporation due to the hydrophilic nature of CMC [48,49]. The second stage occurred at around 160–200°C with a weight loss of 10.6%, possibly due to the plasticizer glycerol’s volatilization [50]. The third stage occurred at approximately 250–400°C, which was probably related to the thermal degradation of intermolecular crosslinking of starch and CMC, which occurs at similar decomposition temperatures [51,52]. The fourth stage occurred at around 450–600°C with a weight loss of 75% and is attributed to the fragmentation of the C–C backbone of the polymers. Furthermore, the TGA thermograms of CMC/starch/TiO2 irradiated at 2.5 and 15 kGy displayed similar behaviour to the CMC/starch blend film, indicating a similar degradation mechanism over four stages in line with increasing temperature. Note that the thermal stability of the irradiated samples increased with the increasing irradiation dose, which could be ascribed to the increased crosslinking reaction induced by irradiation that subsequently limits the mobility and suppresses the chain transfer reaction between the CMC/starch chain and the TiO2 nanoparticles in the film. These results indicate that irradiated CMC/starch/TiO2 films are thermally more stable than CMC/starch films.
3.8 Shelf life of strawberries
Strawberries are one of the most popular and economically essential fruits worldwide. The strawberry is a non-climacteric fruit with a short shelf life, possibly related to its relatively high respiration rate and its sensitivity to fungal decay. It is also characterized by a soft texture that renders it susceptible to water loss and mechanical injury [53]. To investigate the potential effectiveness of surface coating of CMC/starch/TiO2 edible film in extending the shelf life of strawberries, the visual appearance as an essential quality factor was observed every 5 days during the storage time. Four groups of strawberries were used: the first group was untreated and considered to be a control, the second group was packed in a container covered with unirradiated CMC/starch/TiO2 film, the third group was surface coated with unirradiated CMC/starch/TiO2 edible film, and the fourth group was surface coated with CMC/starch/TiO2 edible film irradiated at 15 kGy.
On Day 0, all groups displayed similar appearances with a bright red colour (Figure 8). On Day 5, the control samples became darker with a minor visual fungal decay on the surface, indicating a sign of infection, while the coated samples showed no mould growth and no colour darkening. On Day 10, control samples exhibited tissue softening, browning, and mould growth, whereas the colour of strawberries packed in a container covered with CMC/starch film became slightly darker with a slight mould surface growth.

Appearance of untreated strawberries (control) (a), packed in a container covered with unirradiated CMC/starch/TiO2 film (b), surface coated with unirradiated CMC/starch/TiO2 film (c), and surface coated with irradiated CMC/starch/TiO2 edible film (d) at different storage time.
The softening of strawberries could be ascribed to the degradation of the cortical parenchyma cell wall mediated by enzymatic processes, water loss through respiration, and damage of structural tissues triggered by moulds [54,55]. The colour of the strawberries is an essential aspect of consumer product acceptance. The changes in the surface colour of strawberries during storage could be attributed to the degradation of anthocyanin, which is responsible for their red colour [56]. After 15 days of storage, control samples were damaged entirely, showing a very soft watery texture and a grey colour with mould growth, while the samples coated with unirradiated CMC/starch/TiO2 edible film revealed less spoilage decay than samples packed in a container covered with CMC/starch film. Indeed, the irradiated CMC/starch/TiO2 film showed a superior effect in prolonging the storage life of strawberries as the colour of samples remained constant during the storage time and had an acceptable visual quality with a delay in mould growth.
A mechanism that probably contributed to the efficacy of the CMC/starch/TiO2 edible film in extending the shelf life of strawberries is the potential antimicrobial activity of TiO2. Several studies have proposed numerous mechanisms for TiO2 in inhibiting fungi. It has been reported that chitosan/TiO2 nanocomposite could destroy the fungal cell wall by overexpression of the chitinase enzyme resulting in the degradation of chitin, a vital constituent of the pathogen cell wall and is crucial in achieving the antifungal activity. It was evident that the mortality of mould increased when the content of TiO2 in the composite increased. Furthermore, chitosan/TiO2 could inhibit intracellular calcium, which affects the fungal growth rate [57]. A further possible mechanism for the efficacy of CMC/starch/TiO2 edible film in extending the shelf life of strawberries is the improved mechanical and thermal properties of the irradiated films that provided a mechanical barrier to oxygen and water vapour transmission, slowing the respiration rate of fruits and consequently decreasing weight loss and fruit softening and delaying microbial growth [58].
3.9 Antibacterial activity
The potential to develop low-cost and effective technology to address the harmful impacts of microorganisms associated with food packaging membrane surfaces has received much interest in recent years. Numerous membranes attract microorganisms like bacteria, algae, and diatoms [59].
One of the significant threats in the food packaging industry is the emergence of microbial organisms. Researchers have attempted to develop new, effective antimicrobial reagents that are free of resistance and have a low cost. Such problems and needs have led to a resurgence in nanoparticle-based treatments that may be linked to broad-spectrum activity and a far lower propensity to induce microbial resistance than other methods. Inorganic nanocrystalline metal oxides such as TiO2 are particularly interesting because they can be prepared with high surface areas and are more suitable for biological applications [60]. Nano-sized particles of TiO2 have more pronounced antimicrobial activities than large particles because their small size (less than 100 nm) and the high surface-to-volume ratio of nanoparticles allow for better interaction with bacteria. Recent studies have shown that these nanoparticles have selective toxicity to bacteria but exhibit minimal effects on human cells [61].
TiO2 exhibits significant antimicrobial activities when particle size is reduced to the nanometer range when nano-sized TiO2 can interact with the bacterial surface or the bacterial core where it enters the cell and subsequently exhibits distinct bactericidal mechanisms. The interactions between these unique materials and bacteria are mostly toxic. They have been exploited for antimicrobial applications, such as water treatment, cosmetics, synthetic textiles, and biomedical and surgical devices [62,63].
Many scientists have used TiO2 as an antibacterial against human pathogenic bacteria and fungi [64,65]. Some researchers have observed that nano-TiO2 has antimicrobial activity against human pathogens, and they concluded that the growth inhibition was demonstrated against Bacillus subtilis (24 mm), E. coli (24 mm), S. aureus (22 mm), and Pseudomonas aeruginosa (22 mm) [66].
In this study, the antimicrobial activity of nano-TiO2 as an antimicrobial agent was determined against S. aureus and E. coli. Antifouling activity of the blank CMC/starch and its TiO2 nanoparticles CMC/starch/TiO2 at different irradiation doses (10, 20, and 30 kGy) was tested by measuring the zone of inhibition against the tested microorganisms. The results shown in Figure 9 indicate that the TiO2-nanoparticle-modified membranes showed antibacterial action against Gram-positive organism S. aureus and Gram-negative E.coli with different inhibition zones ranging between 17 and 22 mm in all the used samples. Also, the blank CMC/starch membrane shows antibacterial action against Gram-positive organism S. aureus and Gram-negative E. coli due to the presence of citric acid but with a smaller inhibition zone compared with the modified CMC/starch/TiO2 membranes.
The antimicrobial activity of TiO2 nanoparticles at different irradiation doses against S. aureus (left) and E. coli (right).
In contrast, all modified samples exhibited antimicrobial activity against Gram-negative organism E. coli and Gram-negative S. aureus but with different inhibition zones due to different irradiation doses exposure, which directly impact TiO2 particle sizes. As we discussed previously, the TiO2 particle sizes decreased in response to an increase in the irradiation dose. Consequently, the antibacterial activity of the modified membranes will be increased as shown in Figure 9.
4 Conclusions
Starch and CMC were successfully incorporated with TiO2 nanoparticles in different concentrations via ionizing radiation. The structure of the prepared edible films was confirmed by FTIR analysis. XRD patterns showed a reduction in crystallinity peaks that ascribed the function of CMC/starch/TiO2 film.
TiO2 improved the mechanical properties of the edible film at 30 kGy. TGA revealed that thermal stability was significantly enhanced by adding TiO2 due to hydrogen bonding interaction. The incorporation of TiO2 into CMC/starch edible film displayed a significant inhibitory effect against both Gram-negative E. coli and Gram-positive S. aureus. This explains extending the shelf life of non-climacteric fruits like “strawberries.”
Based on the obtained results, the prepared CMC/starch edible films by ionizing radiation could be considered potential candidates in the field of edible nano-films because of their thermal, mechanical, and antimicrobial properties.
-
Funding information: Authors state no funding involved.
-
Author contributions: Hassan Alzain, Karim Hussein, and Ibrahim Jabr designed the study along with carrying out the research and writing the article.
-
Conflict of interest: The authors of this article are solely responsible for the content thereof. Data, ideas, and opinions presented herein do not necessarily represent the corporate views of the Saudi Arabian Oil Company.
References
[1] Mallick N, Pattanayak DS, Soni A, Pal D. Starch based polymeric composite for food packaging applications. J Eng Res Appl. 2020;10:11–34.Search in Google Scholar
[2] Kouhi M, Prabhakaran MP, Ramakrishna S. Edible polymers: an insight into its application in food, biomedicine and cosmetics. Trends Food Sci Technol. 2020;103:248–63.10.1016/j.tifs.2020.05.025Search in Google Scholar
[3] Soto D, Urdaneta J, Pernía K, León O, Muñoz-Bonilla A, Fernandez-García M. Removal of heavy metal ions in water by starch esters. Starch. 2016;68:37–46.10.1002/star.201500155Search in Google Scholar
[4] Ortega F, Arce VB, Garcia MA. Nanocomposite starch-based films containing silver nanoparticles synthesized with lemon juice as reducing and stabilizing agent. Carbohydr Polym. 2021;252:117208.10.1016/j.carbpol.2020.117208Search in Google Scholar PubMed
[5] Tabari M. Investigation of carboxymethyl cellulose (CMC) on mechanical properties of cold water fish gelatin biodegradable edible films. Foods. 2017;6:4110.3390/foods6060041Search in Google Scholar PubMed PubMed Central
[6] Zhang W, Zhang Y, Cao J, Jiang W. Improving the performance of edible food packaging films by using nanocellulose as an additive. Int J Biol Macromol. 2021;166:288–96.10.1016/j.ijbiomac.2020.10.185Search in Google Scholar PubMed
[7] Ma X, Cheng Y, Qin X, Guo T, Deng J, Liu X. Hydrophilic modification of cellulose nanocrystals improves the physicochemical properties of cassava starchbased nanocomposite films. Food Sci Technol. 2017;86:318–26.10.1016/j.lwt.2017.08.012Search in Google Scholar
[8] Suriyatem R, Auras RA, Rachtanapun P. Utilization of carboxymethyl cellulose from durian rind agricultural waste to improve physical properties and stability of rice starch-based film. J Polym Environ. 2019;27:286–98.10.1007/s10924-018-1343-zSearch in Google Scholar
[9] Sung SY, Sin LT, Tee TT, Bee ST, Rahmat AR, Rahman WAWA, et al. Antimicrobial agents for food packaging applications. Trends Food Sci Technol. 2013;33:110–23.10.1016/j.tifs.2013.08.001Search in Google Scholar
[10] Tong Y, Shi G, Hu G, Hu X, Han L, Xie X, et al. Photo-catalyzed TiO2 inactivates pathogenic viruses by attacking viral genome. Chem Eng J. 2021;414:128788.10.1016/j.cej.2021.128788Search in Google Scholar PubMed PubMed Central
[11] Foster HA, Ditta IB, Varghese S, Steele A. Photocatalytic disinfection using titanium dioxide: spectrum and mechanism of antimicrobial activity. Appl Microbiol Biotechnol. 2011;90:1847–68.10.1007/s00253-011-3213-7Search in Google Scholar PubMed PubMed Central
[12] Ashfaq A, Clochard M, Coqueret X, Dispenza C, Driscoll M, Ulański P, et al. Polymerization reactions and modifications of polymers by ionizing radiation. Polymers. 2020;12:2877.10.3390/polym12122877Search in Google Scholar PubMed PubMed Central
[13] Tong Q, Xiao Q, Lim LT. Preparation and properties of pullulan–alginate–carboxymethyl cellulose blend films. Food Res Int. 2008;41(10):1007–14.10.1016/j.foodres.2008.08.005Search in Google Scholar
[14] Rachtanapun P. Blended films of carboxymethyl cellulose from papaya peel (CMCp) and corn starch. Kasetsart J (Nat Sci). 2009;43:259–66.Search in Google Scholar
[15] Mali KK, Dhawale SC, Dias RJ, Dhane NS, Ghorpade VS. Citric acid crosslinked carboxymethyl cellulose-based composite hydrogel films for drug delivery. Ind J Pharm Sci. 2018;80:657–67.10.4172/pharmaceutical-sciences.1000405Search in Google Scholar
[16] Biswal DR, Singh RP. Characterization of carboxymethyl cellulose and polyacrylamide graft copolymer. Carbohydr Polym. 2004;57:379–87.10.1016/j.carbpol.2004.04.020Search in Google Scholar
[17] Tongdeesoontorn W, Mauer LJ, Wongruong S, Sriburi P, Rachtanapun P. Effect of carboxymethyl cellulose concentration on physical properties of biodegradable cassava starch-based films. Chem Cent J. 2011;5:1–8.10.1186/1752-153X-5-6Search in Google Scholar PubMed PubMed Central
[18] Tavares KM, de Campos A, Mitsuyuki MC, Luchesi BR, Marconcini JM. Corn and cassava starch with carboxymethyl cellulose films and its mechanical hydrophobic properties. Carbohydr Polym. 2019;223:115055.10.1016/j.carbpol.2019.115055Search in Google Scholar PubMed
[19] Alsharaeh EH, Bora T, Soliman A, Ahmed F, Bharath G, Ghoniem MG, et al. Sol–gel-assisted microwave-derived synthesis of anatase Ag/TiO2/GO nanohybrids toward efficient visible light phenol degradation. Catalysts. 2017;7(5):133.10.3390/catal7050133Search in Google Scholar
[20] Damodar RA, You SJ, Chou HH. Study the self-cleaning, antibacterial and photocatalytic properties of TiO2 entrapped PVDF membranes. J Hazard Mater. 2009;172(2–3):1321–8.10.1016/j.jhazmat.2009.07.139Search in Google Scholar PubMed
[21] Thamaphat K, Limsuwan P, Ngotawornchai BK. Phase transition of TiO2 powder by XRD and TEM. Kasetsart J (Nat Sci). 2008;42:357e361.Search in Google Scholar
[22] Tavares KM, Campos A, Luchesi B, Resende A, Elvis de Oliveira J, Marconcini J. Effect of carboxymethyl cellulose concentration on mechanical and water vapor barrier properties of corn starch films. Carbohydr Polym. 2020;246:116521.10.1016/j.carbpol.2020.116521Search in Google Scholar PubMed
[23] Aguilera-Aguirre S, Pérez-Larios A, Montalvo-González E. Fabrication, characterization and Raman study of TiO2 nanowire arrays prepared by anodic oxidative hydrolysis of TiCl3. Chem Phys Lett. 2001;338(4–6):231–6.10.1016/S0009-2614(01)00263-9Search in Google Scholar
[24] Oleyaei SA, Almasi H, Ghanbarzadeh B, Moayedi AA. Synergistic reinforcing effect of TiO2 and montmorillonite on potato starch nanocomposite films: thermal, mechanical and barrier properties. Carbohydr Polym. 2016a;152:253–62.10.1016/j.carbpol.2016.07.040Search in Google Scholar PubMed
[25] Oleyaei SA, Zahedi Y, Ghanbarzadeh B, Moayedi AA. Modification of physicochemical and thermal properties of starch films by incorporation of TiO2 nanoparticles. Int J Biol Macromol. 2016b;89:256–64.10.1016/j.ijbiomac.2016.04.078Search in Google Scholar PubMed
[26] Anaya-Esparza LM, Ruvalcaba-Gómez JM, Maytorena-Verdugo CI, González-Silva N, Romero-Toledo R. Chitosan–TiO2: a versatile hybrid composite: a review. Materials. 2020;13:811.10.3390/ma13040811Search in Google Scholar PubMed PubMed Central
[27] Venkatachalam S, Mangalaraj D, Narayandass SK, Kim K, Yi J. Structure, optical and electrical properties of ZnSe thin films. Phys B. 2005;358:27e35.10.1016/j.physb.2004.12.022Search in Google Scholar
[28] Pasanphan W, Rimdusit P, Choofong S, Piroonpan T, Nilsuwankosit S. Systematic fabrication of chitosan nanoparticle by gamma irradiation. Radiat Phys Chem. 2010;79:1095–102.10.1016/j.radphyschem.2010.04.003Search in Google Scholar
[29] Albukhaty S, Al-Bayati L, Al-Karagoly H, Al-Musawi S. Preparation and characterization of titanium dioxide nanoparticles and in vitro investigation of their cytotoxicity and antibacterial activity against Staphylococcus aureus and Escherichia coli. Anim Biotechnol. 2020;33:1–7.10.1080/10495398.2020.1842751Search in Google Scholar PubMed
[30] Radwan R, Abdel Ghaffar A, Ali H. Gamma radiation preparation of chitosan nanoparticles for controlled delivery of memantine. J Biomater Appl. 2020;34(8):1150–62.10.1177/0885328219890071Search in Google Scholar PubMed
[31] Radwan R, Ali H. Radiation-synthesis of chitosan/poly (acrylic acid) nanogel for improving the antitumor potential of rutin in hepatocellular carcinoma. Drug Delivery Transl Res. 2021;11:261–78.10.1007/s13346-020-00792-7Search in Google Scholar PubMed
[32] Wilpiszewska K, Antosik A, Schmidt B, Janik J, Rokicka J. Hydrophilic films based on carboxymethylated derivatives of starch and cellulose. Polymers. 2020;12:2447.10.3390/polym12112447Search in Google Scholar PubMed PubMed Central
[33] Yoon SD, Chough SH, Park HR. Preparation of resistant starch/poly(vinyl alcohol) blend films with added plasticizer and crosslinking agents. J Appl Polym Sci. 2007;96:1394–7.10.1002/app.26755Search in Google Scholar
[34] Suriyatem R, Auras RA, Rachtanapun P, Suriyatem R, Auras RA, Rachtanapun P. Improvement of mechanical properties and thermal stability of biodegradable rice starch-based films blended with carboxymethyl chitosan. Ind Crop Products. 2018;122:37–48.10.1016/j.indcrop.2018.05.047Search in Google Scholar
[35] He J, Wang Y, Cui S, Gao Y, Wang S. Structure and properties of silk fibroin/carboxymethyl chitosan blend films. Polym Bull. 2010;65:395–409.10.1007/s00289-010-0293-ySearch in Google Scholar
[36] Ali HE, Abdel Ghaffar AM. Preparation and effect of gamma radiation on the properties and biodegradability of poly(styrene/starch) blends. Radiat Phys Chem1. 2017;30:411–20.10.1016/j.radphyschem.2016.09.006Search in Google Scholar
[37] Sangroniz A, Zhu J-B, Tang X, Etxeberria A, Chen EY-X, Sardon H. Packaging materials with desired mechanical and barrier properties and full chemical recyclability. Nat Commun. 2019;10:3559.10.1038/s41467-019-11525-xSearch in Google Scholar PubMed PubMed Central
[38] Othman SH. Bio-nanocomposite materials for food packaging applications: types of biopolymer and nano-sized filler. Agric Agric Sci Procedia. 2014;2:296–303.10.1016/j.aaspro.2014.11.042Search in Google Scholar
[39] Ballesteros-Mártinez L, Pérez-Cervera C, Andrade-Pizarro R. Effect of glycerol and sorbitol concentrations on mechanical, optical, and barrier properties of sweet potato starch film. NFS J. 2020;20:1–9.10.1016/j.nfs.2020.06.002Search in Google Scholar
[40] Ghanbarzadeh B, Almasi H, Entezami AA. Physical properties of edible modified starch/carboxymethyl cellulose films. Innov Food Sci Emerg Technol. 2010;11:697–702.10.1016/j.ifset.2010.06.001Search in Google Scholar
[41] Putri DA, Setiawan A, Anggraini PD. Physical properties of edible sorghum starch film added with carboxymethyl cellulose. J Phys Sci. 2018;29:185–94.10.21315/jps2018.29.s2.14Search in Google Scholar
[42] Ban W, Song J, Argyropoulos DS, Lucia LA. Improving the physical and chemical functionally of starch-derived films with biopolymers. J Appl Polym Sci. 2005;100(3):2542–8.10.1002/app.23698Search in Google Scholar
[43] Li MC, Mei C, Xu X, Lee S, Wu Q. Cationic surface modification of cellulose nanocrystals: toward tailoring dispersion and interface in carboxymethyl cellulose films. Polymer. 2016;107:200–10.10.1016/j.polymer.2016.11.022Search in Google Scholar
[44] Wu L, Lin X, Zhou X, Luo X. Removal of uranium and fluorine from wastewater by double-functional microsphere adsorbent of SA/CMC loaded with calcium and aluminum. Appl Surf Sci. 2016;384:466–79.10.1016/j.apsusc.2016.05.056Search in Google Scholar
[45] Mathew S, Abraham ET. Characterisation of ferulic acid incorporated starch–chitosan blend films. Food Hydrocoll. 2008;22:826–35.10.1016/j.foodhyd.2007.03.012Search in Google Scholar
[46] Garcia M, Martino M, Zaritzky N. Microstructural characterization of plasticized starch-based films. Starch-Stärke. 2000;52:118–24.10.1002/1521-379X(200006)52:4<118::AID-STAR118>3.0.CO;2-0Search in Google Scholar
[47] Wu S, Chen X, Yi M, Ge J, Yin G, Li X, et al. Improving thermal, mechanical, and barrier properties of feather keratin/polyvinyl alcohol/tris(hydroxymethyl) aminomethane nanocomposite films by incorporating sodium montmorillonite and TiO2. Nanomaterials. 2019;9:298.10.3390/nano9020298Search in Google Scholar
[48] Coelho C, Tonon RV, Cabral LMC, Freitas-Silva O, Michelin M, Vicente AA, et al. Cellulose nanocrystals from grape pomace: production, properties and cytotoxicity assessment. Carbohydr Polym. 2018;192:327–36.10.1016/j.carbpol.2018.03.023Search in Google Scholar
[49] Prado K, Spinacé M. Isolation and characterization of cellulose nanocrystals from pineapple crown waste and their potential uses. Int J Biol Macromol. 2019;122:410–6.10.1016/j.ijbiomac.2018.10.187Search in Google Scholar
[50] Jahed E, Khaledabad MA, Almasi H, Hasanzadeh R. Physicochemical properties of Carum copticum essential oil loaded chitosan films containing organic nanoreinforcements. Carbohydr Polym. 2017;164:325–38.10.1016/j.carbpol.2017.02.022Search in Google Scholar
[51] Jaramillo CM, Guitiérrez TJ, Goyanes S, Bernal C, Famá L. Biodegradability and plasticizing effect of yerba mate extract on cassava starch edible films. Carbohydr Polym. 2016;151:150–9.10.1016/j.carbpol.2016.05.025Search in Google Scholar
[52] Rico M, Rodríguez-Llamazares S, Barral L, Bouza R, Montero B. Processing and characterization of polyols plasticized-starch reinforced with microcrystalline cellulose. Carbohydr Polym. 2016;149:83–93.10.1016/j.carbpol.2016.04.087Search in Google Scholar
[53] Campaniello D, Bevilacqua A, Sinigaglia M, Corbo MR. Chitosan: antimicrobial activity and potential applications for preserving minimally processed strawberries. Food Microbiol. 2008;25:992–1000.10.1016/j.fm.2008.06.009Search in Google Scholar
[54] Fan Y, Xu Y, Wang D, Zhang L, Sun J, Sun L, et al. Effect of alginate coating combined with yeast antagonist on strawberry (Fragaria × ananassa) preservation quality. Postharvest Biol Technol. 2009;53:84–90.10.1016/j.postharvbio.2009.03.002Search in Google Scholar
[55] Atress ASH, El-Mogy MM, Aboul-Anean HE, Alsanius BW. Improving strawberry fruit storability by edible coating as a carrier of thymol or calcium chloride. J Hortic Sci Ornam Plants. 2010;2:88–97.Search in Google Scholar
[56] Peretto G, Du W-X, Avena-Bustillos RJ, Sarreal SBL, Hua SST, Sambo P, et al. Increasing strawberry shelf-life with carvacrol and methyl cinnamate antimicrobial vapors released from edible films. Postharvest Biol Technol. 2014;89:11–8.10.1016/j.postharvbio.2013.11.003Search in Google Scholar
[57] Xing Y, Yi R, Yang H, Xu Q, Huang R, Tang J, et al. Antifungal effect of chitosan/Nano-TiO2 composite coatings against Colletotrichum gloeosporioides, Cladosporium oxysporum and Penicillium steckii. Molecules. 2021;26:4401.10.3390/molecules26154401Search in Google Scholar PubMed PubMed Central
[58] Eroglu E, Torun M, Dincer C, Topuz A. Influence of pullulan-based edible coating on some quality properties of strawberry during cold storage. Packag Technol Sci. 2014;27:831–8.10.1002/pts.2077Search in Google Scholar
[59] Creber SA, Vrouwenvelder JS, Loosdrecht MCM, Johns ML. Chemical cleaning of biofouling in reverse osmosis membranes evaluated using magnetic resonance imaging. J Membr Sci. 2010;362:202–10.10.1016/j.memsci.2010.06.052Search in Google Scholar
[60] Vani C, Sergin GK, Annamalai A. A study on the effect of zinc oxide nano particles in Staphylococcus aureus. Int J Pharma Bio Sci. 2011;2:326–35.Search in Google Scholar
[61] Reddy KM. Selective toxicity of zinc oxide nano particles to prokaryotic and eukaryotic systems. Appl Phys Lett. 2007;90:2139021–3.10.1063/1.2742324Search in Google Scholar PubMed PubMed Central
[62] Martinez-Gutierrez F, Olive PL, Banuelos A, Orrantia E, Nino N, Sanchez EM, et al. Synthesis, characterization and evaluation of antimicrobial and cytotoxic effect of silver and titanium nano particles. Nanomedicine. 2010;6:681–8.10.1016/j.nano.2010.02.001Search in Google Scholar PubMed
[63] Seil JT, Webster TJ. Antimicrobial applications of nanotechnology: methods and literature. Int J Nanomed. 2012;7:2767–81. 10.2147/IJN.S24805.Search in Google Scholar PubMed PubMed Central
[64] Meruvu H, Vangalapati M, Chippada SC, Bammidi SR. Synthesis and characterization of zinc oxide nanoparticles and its antimicrobial activity against Bacillus Subtilis and Escherichia Coli. Rasayan J Chem. 2011;4:217–22.Search in Google Scholar
[65] Gunalan S, Sivaraj R, Rajendran V. Green synthesized ZnO nanoparticles against bacterial and fungal pathogens. Prog Nat Sci, Mater Int. 2012;6:693–700.10.1016/j.pnsc.2012.11.015Search in Google Scholar
[66] El-sayed EH, Shokry HH, Elkady MF, Eslam S. Assessment of antibacterial activity for synthesized zinc oxide nanorods against plant pathogenic strains. Int J Sci Technol Res. 2014;3:318–24.Search in Google Scholar
© 2022 the author(s), published by De Gruyter
This work is licensed under the Creative Commons Attribution 4.0 International License.
Articles in the same Issue
- Research Articles
- Kinetic study on the reaction between Incoloy 825 alloy and low-fluoride slag for electroslag remelting
- Black pepper (Piper nigrum) fruit-based gold nanoparticles (BP-AuNPs): Synthesis, characterization, biological activities, and catalytic applications – A green approach
- Protective role of foliar application of green-synthesized silver nanoparticles against wheat stripe rust disease caused by Puccinia striiformis
- Effects of nitrogen and phosphorus on Microcystis aeruginosa growth and microcystin production
- Efficient degradation of methyl orange and methylene blue in aqueous solution using a novel Fenton-like catalyst of CuCo-ZIFs
- Synthesis of biological base oils by a green process
- Efficient pilot-scale synthesis of the key cefonicid intermediate at room temperature
- Synthesis and characterization of noble metal/metal oxide nanoparticles and their potential antidiabetic effect on biochemical parameters and wound healing
- Regioselectivity in the reaction of 5-amino-3-anilino-1H-pyrazole-4-carbonitrile with cinnamonitriles and enaminones: Synthesis of functionally substituted pyrazolo[1,5-a]pyrimidine derivatives
- A numerical study on the in-nozzle cavitating flow and near-field atomization of cylindrical, V-type, and Y-type intersecting hole nozzles using the LES-VOF method
- Synthesis and characterization of Ce-doped TiO2 nanoparticles and their enhanced anticancer activity in Y79 retinoblastoma cancer cells
- Aspects of the physiochemical properties of SARS-CoV-2 to prevent S-protein receptor binding using Arabic gum
- Sonochemical synthesis of protein microcapsules loaded with traditional Chinese herb extracts
- MW-assisted hydrolysis of phosphinates in the presence of PTSA as the catalyst, and as a MW absorber
- Fabrication of silicotungstic acid immobilized on Ce-based MOF and embedded in Zr-based MOF matrix for green fatty acid esterification
- Superior photocatalytic degradation performance for gaseous toluene by 3D g-C3N4-reduced graphene oxide gels
- Catalytic performance of Na/Ca-based fluxes for coal char gasification
- Slow pyrolysis of waste navel orange peels with metal oxide catalysts to produce high-grade bio-oil
- Development and butyrylcholinesterase/monoamine oxidase inhibition potential of PVA-Berberis lycium nanofibers
- Influence of biosynthesized silver nanoparticles using red alga Corallina elongata on broiler chicks’ performance
- Green synthesis, characterization, cytotoxicity, and antimicrobial activity of iron oxide nanoparticles using Nigella sativa seed extract
- Vitamin supplements enhance Spirulina platensis biomass and phytochemical contents
- Malachite green dye removal using ceramsite-supported nanoscale zero-valent iron in a fixed-bed reactor
- Green synthesis of manganese-doped superparamagnetic iron oxide nanoparticles for the effective removal of Pb(ii) from aqueous solutions
- Desalination technology for energy-efficient and low-cost water production: A bibliometric analysis
- Biological fabrication of zinc oxide nanoparticles from Nepeta cataria potentially produces apoptosis through inhibition of proliferative markers in ovarian cancer
- Effect of stabilizers on Mn ZnSe quantum dots synthesized by using green method
- Calcium oxide addition and ultrasonic pretreatment-assisted hydrothermal carbonization of granatum for adsorption of lead
- Fe3O4@SiO2 nanoflakes synthesized using biogenic silica from Salacca zalacca leaf ash and the mechanistic insight into adsorption and photocatalytic wet peroxidation of dye
- Facile route of synthesis of silver nanoparticles templated bacterial cellulose, characterization, and its antibacterial application
- Synergistic in vitro anticancer actions of decorated selenium nanoparticles with fucoidan/Reishi extract against colorectal adenocarcinoma cells
- Preparation of the micro-size flake silver powders by using a micro-jet reactor
- Effect of direct coal liquefaction residue on the properties of fine blue-coke-based activated coke
- Integration of microwave co-torrefaction with helical lift for pellet fuel production
- Cytotoxicity of green-synthesized silver nanoparticles by Adansonia digitata fruit extract against HTC116 and SW480 human colon cancer cell lines
- Optimization of biochar preparation process and carbon sequestration effect of pruned wolfberry branches
- Anticancer potential of biogenic silver nanoparticles using the stem extract of Commiphora gileadensis against human colon cancer cells
- Fabrication and characterization of lysine hydrochloride Cu(ii) complexes and their potential for bombing bacterial resistance
- First report of biocellulose production by an indigenous yeast, Pichia kudriavzevii USM-YBP2
- Biosynthesis and characterization of silver nanoparticles prepared using seeds of Sisymbrium irio and evaluation of their antifungal and cytotoxic activities
- Synthesis, characterization, and photocatalysis of a rare-earth cerium/silver/zinc oxide inorganic nanocomposite
- Developing a plastic cycle toward circular economy practice
- Fabrication of CsPb1−xMnxBr3−2xCl2x (x = 0–0.5) quantum dots for near UV photodetector application
- Anti-colon cancer activities of green-synthesized Moringa oleifera–AgNPs against human colon cancer cells
- Phosphorus removal from aqueous solution by adsorption using wetland-based biochar: Batch experiment
- A low-cost and eco-friendly fabrication of an MCDI-utilized PVA/SSA/GA cation exchange membrane
- Synthesis, microstructure, and phase transition characteristics of Gd/Nd-doped nano VO2 powders
- Biomediated synthesis of ZnO quantum dots decorated attapulgite nanocomposites for improved antibacterial properties
- Preparation of metal–organic frameworks by microwave-assisted ball milling for the removal of CR from wastewater
- A green approach in the biological base oil process
- A cost-effective and eco-friendly biosorption technology for complete removal of nickel ions from an aqueous solution: Optimization of process variables
- Protective role of Spirulina platensis liquid extract against salinity stress effects on Triticum aestivum L.
- Comprehensive physical and chemical characterization highlights the uniqueness of enzymatic gelatin in terms of surface properties
- Effectiveness of different accelerated green synthesis methods in zinc oxide nanoparticles using red pepper extract: Synthesis and characterization
- Blueprinting morpho-anatomical episodes via green silver nanoparticles foliation
- A numerical study on the effects of bowl and nozzle geometry on performances of an engine fueled with diesel or bio-diesel fuels
- Liquid-phase hydrogenation of carbon tetrachloride catalyzed by three-dimensional graphene-supported palladium catalyst
- The catalytic performance of acid-modified Hβ molecular sieves for environmentally friendly acylation of 2-methylnaphthalene
- A study of the precipitation of cerium oxide synthesized from rare earth sources used as the catalyst for biodiesel production
- Larvicidal potential of Cipadessa baccifera leaf extract-synthesized zinc nanoparticles against three major mosquito vectors
- Fabrication of green nanoinsecticides from agri-waste of corn silk and its larvicidal and antibiofilm properties
- Palladium-mediated base-free and solvent-free synthesis of aromatic azo compounds from anilines catalyzed by copper acetate
- Study on the functionalization of activated carbon and the effect of binder toward capacitive deionization application
- Co-chlorination of low-density polyethylene in paraffin: An intensified green process alternative to conventional solvent-based chlorination
- Antioxidant and photocatalytic properties of zinc oxide nanoparticles phyto-fabricated using the aqueous leaf extract of Sida acuta
- Recovery of cobalt from spent lithium-ion battery cathode materials by using choline chloride-based deep eutectic solvent
- Synthesis of insoluble sulfur and development of green technology based on Aspen Plus simulation
- Photodegradation of methyl orange under solar irradiation on Fe-doped ZnO nanoparticles synthesized using wild olive leaf extract
- A facile and universal method to purify silica from natural sand
- Green synthesis of silver nanoparticles using Atalantia monophylla: A potential eco-friendly agent for controlling blood-sucking vectors
- Endophytic bacterial strain, Brevibacillus brevis-mediated green synthesis of copper oxide nanoparticles, characterization, antifungal, in vitro cytotoxicity, and larvicidal activity
- Off-gas detection and treatment for green air-plasma process
- Ultrasonic-assisted food grade nanoemulsion preparation from clove bud essential oil and evaluation of its antioxidant and antibacterial activity
- Construction of mercury ion fluorescence system in water samples and art materials and fluorescence detection method for rhodamine B derivatives
- Hydroxyapatite/TPU/PLA nanocomposites: Morphological, dynamic-mechanical, and thermal study
- Potential of anaerobic co-digestion of acidic fruit processing waste and waste-activated sludge for biogas production
- Synthesis and characterization of ZnO–TiO2–chitosan–escin metallic nanocomposites: Evaluation of their antimicrobial and anticancer activities
- Nitrogen removal characteristics of wet–dry alternative constructed wetlands
- Structural properties and reactivity variations of wheat straw char catalysts in volatile reforming
- Microfluidic plasma: Novel process intensification strategy
- Antibacterial and photocatalytic activity of visible-light-induced synthesized gold nanoparticles by using Lantana camara flower extract
- Antimicrobial edible materials via nano-modifications for food safety applications
- Biosynthesis of nano-curcumin/nano-selenium composite and their potentialities as bactericides against fish-borne pathogens
- Exploring the effect of silver nanoparticles on gene expression in colon cancer cell line HCT116
- Chemical synthesis, characterization, and dose optimization of chitosan-based nanoparticles of clodinofop propargyl and fenoxaprop-p-ethyl for management of Phalaris minor (little seed canary grass): First report
- Double [3 + 2] cycloadditions for diastereoselective synthesis of spirooxindole pyrrolizidines
- Green synthesis of silver nanoparticles and their antibacterial activities
- Review Articles
- A comprehensive review on green synthesis of titanium dioxide nanoparticles and their diverse biomedical applications
- Applications of polyaniline-impregnated silica gel-based nanocomposites in wastewater treatment as an efficient adsorbent of some important organic dyes
- Green synthesis of nano-propolis and nanoparticles (Se and Ag) from ethanolic extract of propolis, their biochemical characterization: A review
- Advances in novel activation methods to perform green organic synthesis using recyclable heteropolyacid catalysis
- Limitations of nanomaterials insights in green chemistry sustainable route: Review on novel applications
- Special Issue: Use of magnetic resonance in profiling bioactive metabolites and its applications (Guest Editors: Plalanoivel Velmurugan et al.)
- Stomach-affecting intestinal parasites as a precursor model of Pheretima posthuma treated with anthelmintic drug from Dodonaea viscosa Linn.
- Anti-asthmatic activity of Saudi herbal composites from plants Bacopa monnieri and Euphorbia hirta on Guinea pigs
- Embedding green synthesized zinc oxide nanoparticles in cotton fabrics and assessment of their antibacterial wound healing and cytotoxic properties: An eco-friendly approach
- Synthetic pathway of 2-fluoro-N,N-diphenylbenzamide with opto-electrical properties: NMR, FT-IR, UV-Vis spectroscopic, and DFT computational studies of the first-order nonlinear optical organic single crystal
Articles in the same Issue
- Research Articles
- Kinetic study on the reaction between Incoloy 825 alloy and low-fluoride slag for electroslag remelting
- Black pepper (Piper nigrum) fruit-based gold nanoparticles (BP-AuNPs): Synthesis, characterization, biological activities, and catalytic applications – A green approach
- Protective role of foliar application of green-synthesized silver nanoparticles against wheat stripe rust disease caused by Puccinia striiformis
- Effects of nitrogen and phosphorus on Microcystis aeruginosa growth and microcystin production
- Efficient degradation of methyl orange and methylene blue in aqueous solution using a novel Fenton-like catalyst of CuCo-ZIFs
- Synthesis of biological base oils by a green process
- Efficient pilot-scale synthesis of the key cefonicid intermediate at room temperature
- Synthesis and characterization of noble metal/metal oxide nanoparticles and their potential antidiabetic effect on biochemical parameters and wound healing
- Regioselectivity in the reaction of 5-amino-3-anilino-1H-pyrazole-4-carbonitrile with cinnamonitriles and enaminones: Synthesis of functionally substituted pyrazolo[1,5-a]pyrimidine derivatives
- A numerical study on the in-nozzle cavitating flow and near-field atomization of cylindrical, V-type, and Y-type intersecting hole nozzles using the LES-VOF method
- Synthesis and characterization of Ce-doped TiO2 nanoparticles and their enhanced anticancer activity in Y79 retinoblastoma cancer cells
- Aspects of the physiochemical properties of SARS-CoV-2 to prevent S-protein receptor binding using Arabic gum
- Sonochemical synthesis of protein microcapsules loaded with traditional Chinese herb extracts
- MW-assisted hydrolysis of phosphinates in the presence of PTSA as the catalyst, and as a MW absorber
- Fabrication of silicotungstic acid immobilized on Ce-based MOF and embedded in Zr-based MOF matrix for green fatty acid esterification
- Superior photocatalytic degradation performance for gaseous toluene by 3D g-C3N4-reduced graphene oxide gels
- Catalytic performance of Na/Ca-based fluxes for coal char gasification
- Slow pyrolysis of waste navel orange peels with metal oxide catalysts to produce high-grade bio-oil
- Development and butyrylcholinesterase/monoamine oxidase inhibition potential of PVA-Berberis lycium nanofibers
- Influence of biosynthesized silver nanoparticles using red alga Corallina elongata on broiler chicks’ performance
- Green synthesis, characterization, cytotoxicity, and antimicrobial activity of iron oxide nanoparticles using Nigella sativa seed extract
- Vitamin supplements enhance Spirulina platensis biomass and phytochemical contents
- Malachite green dye removal using ceramsite-supported nanoscale zero-valent iron in a fixed-bed reactor
- Green synthesis of manganese-doped superparamagnetic iron oxide nanoparticles for the effective removal of Pb(ii) from aqueous solutions
- Desalination technology for energy-efficient and low-cost water production: A bibliometric analysis
- Biological fabrication of zinc oxide nanoparticles from Nepeta cataria potentially produces apoptosis through inhibition of proliferative markers in ovarian cancer
- Effect of stabilizers on Mn ZnSe quantum dots synthesized by using green method
- Calcium oxide addition and ultrasonic pretreatment-assisted hydrothermal carbonization of granatum for adsorption of lead
- Fe3O4@SiO2 nanoflakes synthesized using biogenic silica from Salacca zalacca leaf ash and the mechanistic insight into adsorption and photocatalytic wet peroxidation of dye
- Facile route of synthesis of silver nanoparticles templated bacterial cellulose, characterization, and its antibacterial application
- Synergistic in vitro anticancer actions of decorated selenium nanoparticles with fucoidan/Reishi extract against colorectal adenocarcinoma cells
- Preparation of the micro-size flake silver powders by using a micro-jet reactor
- Effect of direct coal liquefaction residue on the properties of fine blue-coke-based activated coke
- Integration of microwave co-torrefaction with helical lift for pellet fuel production
- Cytotoxicity of green-synthesized silver nanoparticles by Adansonia digitata fruit extract against HTC116 and SW480 human colon cancer cell lines
- Optimization of biochar preparation process and carbon sequestration effect of pruned wolfberry branches
- Anticancer potential of biogenic silver nanoparticles using the stem extract of Commiphora gileadensis against human colon cancer cells
- Fabrication and characterization of lysine hydrochloride Cu(ii) complexes and their potential for bombing bacterial resistance
- First report of biocellulose production by an indigenous yeast, Pichia kudriavzevii USM-YBP2
- Biosynthesis and characterization of silver nanoparticles prepared using seeds of Sisymbrium irio and evaluation of their antifungal and cytotoxic activities
- Synthesis, characterization, and photocatalysis of a rare-earth cerium/silver/zinc oxide inorganic nanocomposite
- Developing a plastic cycle toward circular economy practice
- Fabrication of CsPb1−xMnxBr3−2xCl2x (x = 0–0.5) quantum dots for near UV photodetector application
- Anti-colon cancer activities of green-synthesized Moringa oleifera–AgNPs against human colon cancer cells
- Phosphorus removal from aqueous solution by adsorption using wetland-based biochar: Batch experiment
- A low-cost and eco-friendly fabrication of an MCDI-utilized PVA/SSA/GA cation exchange membrane
- Synthesis, microstructure, and phase transition characteristics of Gd/Nd-doped nano VO2 powders
- Biomediated synthesis of ZnO quantum dots decorated attapulgite nanocomposites for improved antibacterial properties
- Preparation of metal–organic frameworks by microwave-assisted ball milling for the removal of CR from wastewater
- A green approach in the biological base oil process
- A cost-effective and eco-friendly biosorption technology for complete removal of nickel ions from an aqueous solution: Optimization of process variables
- Protective role of Spirulina platensis liquid extract against salinity stress effects on Triticum aestivum L.
- Comprehensive physical and chemical characterization highlights the uniqueness of enzymatic gelatin in terms of surface properties
- Effectiveness of different accelerated green synthesis methods in zinc oxide nanoparticles using red pepper extract: Synthesis and characterization
- Blueprinting morpho-anatomical episodes via green silver nanoparticles foliation
- A numerical study on the effects of bowl and nozzle geometry on performances of an engine fueled with diesel or bio-diesel fuels
- Liquid-phase hydrogenation of carbon tetrachloride catalyzed by three-dimensional graphene-supported palladium catalyst
- The catalytic performance of acid-modified Hβ molecular sieves for environmentally friendly acylation of 2-methylnaphthalene
- A study of the precipitation of cerium oxide synthesized from rare earth sources used as the catalyst for biodiesel production
- Larvicidal potential of Cipadessa baccifera leaf extract-synthesized zinc nanoparticles against three major mosquito vectors
- Fabrication of green nanoinsecticides from agri-waste of corn silk and its larvicidal and antibiofilm properties
- Palladium-mediated base-free and solvent-free synthesis of aromatic azo compounds from anilines catalyzed by copper acetate
- Study on the functionalization of activated carbon and the effect of binder toward capacitive deionization application
- Co-chlorination of low-density polyethylene in paraffin: An intensified green process alternative to conventional solvent-based chlorination
- Antioxidant and photocatalytic properties of zinc oxide nanoparticles phyto-fabricated using the aqueous leaf extract of Sida acuta
- Recovery of cobalt from spent lithium-ion battery cathode materials by using choline chloride-based deep eutectic solvent
- Synthesis of insoluble sulfur and development of green technology based on Aspen Plus simulation
- Photodegradation of methyl orange under solar irradiation on Fe-doped ZnO nanoparticles synthesized using wild olive leaf extract
- A facile and universal method to purify silica from natural sand
- Green synthesis of silver nanoparticles using Atalantia monophylla: A potential eco-friendly agent for controlling blood-sucking vectors
- Endophytic bacterial strain, Brevibacillus brevis-mediated green synthesis of copper oxide nanoparticles, characterization, antifungal, in vitro cytotoxicity, and larvicidal activity
- Off-gas detection and treatment for green air-plasma process
- Ultrasonic-assisted food grade nanoemulsion preparation from clove bud essential oil and evaluation of its antioxidant and antibacterial activity
- Construction of mercury ion fluorescence system in water samples and art materials and fluorescence detection method for rhodamine B derivatives
- Hydroxyapatite/TPU/PLA nanocomposites: Morphological, dynamic-mechanical, and thermal study
- Potential of anaerobic co-digestion of acidic fruit processing waste and waste-activated sludge for biogas production
- Synthesis and characterization of ZnO–TiO2–chitosan–escin metallic nanocomposites: Evaluation of their antimicrobial and anticancer activities
- Nitrogen removal characteristics of wet–dry alternative constructed wetlands
- Structural properties and reactivity variations of wheat straw char catalysts in volatile reforming
- Microfluidic plasma: Novel process intensification strategy
- Antibacterial and photocatalytic activity of visible-light-induced synthesized gold nanoparticles by using Lantana camara flower extract
- Antimicrobial edible materials via nano-modifications for food safety applications
- Biosynthesis of nano-curcumin/nano-selenium composite and their potentialities as bactericides against fish-borne pathogens
- Exploring the effect of silver nanoparticles on gene expression in colon cancer cell line HCT116
- Chemical synthesis, characterization, and dose optimization of chitosan-based nanoparticles of clodinofop propargyl and fenoxaprop-p-ethyl for management of Phalaris minor (little seed canary grass): First report
- Double [3 + 2] cycloadditions for diastereoselective synthesis of spirooxindole pyrrolizidines
- Green synthesis of silver nanoparticles and their antibacterial activities
- Review Articles
- A comprehensive review on green synthesis of titanium dioxide nanoparticles and their diverse biomedical applications
- Applications of polyaniline-impregnated silica gel-based nanocomposites in wastewater treatment as an efficient adsorbent of some important organic dyes
- Green synthesis of nano-propolis and nanoparticles (Se and Ag) from ethanolic extract of propolis, their biochemical characterization: A review
- Advances in novel activation methods to perform green organic synthesis using recyclable heteropolyacid catalysis
- Limitations of nanomaterials insights in green chemistry sustainable route: Review on novel applications
- Special Issue: Use of magnetic resonance in profiling bioactive metabolites and its applications (Guest Editors: Plalanoivel Velmurugan et al.)
- Stomach-affecting intestinal parasites as a precursor model of Pheretima posthuma treated with anthelmintic drug from Dodonaea viscosa Linn.
- Anti-asthmatic activity of Saudi herbal composites from plants Bacopa monnieri and Euphorbia hirta on Guinea pigs
- Embedding green synthesized zinc oxide nanoparticles in cotton fabrics and assessment of their antibacterial wound healing and cytotoxic properties: An eco-friendly approach
- Synthetic pathway of 2-fluoro-N,N-diphenylbenzamide with opto-electrical properties: NMR, FT-IR, UV-Vis spectroscopic, and DFT computational studies of the first-order nonlinear optical organic single crystal